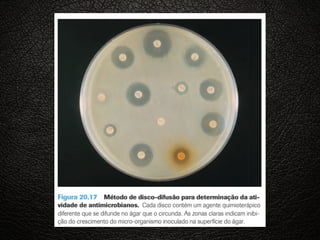
BACTERIAS

Incorporar apresentação
Transferir como PDF, PPTX
















As células bacterianas podem ter diferentes formas e estruturas, incluindo flagelos para movimento, e são classificadas como Gram-positivas ou Gram-negativas dependendo de como absorvem corantes durante a coloração de Gram.